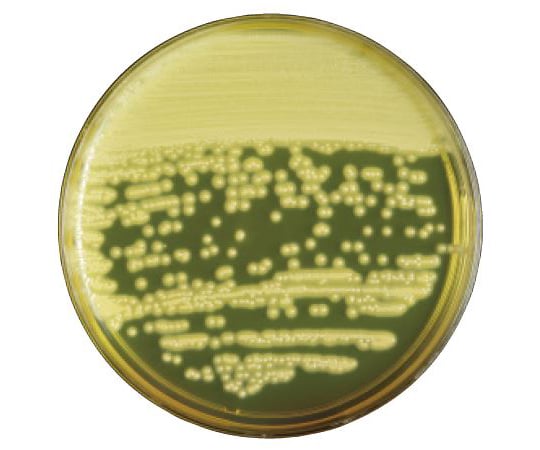

![[SS限定]全品5%OFFクーポン 【新商品】 NERUS ふわとろ毛布 Air AirPremium 【正規品】 毛布 ブランケット もこもこ毛布 モコモコ とろとろ ふわふわ シングル セミダブル ダブル ハーフ ふわもこ ふわとろ ポコポコ ひざ掛け 2枚合わせ 6層 厚手 秋冬 Branchpoint](https://thumbnail.image.rakuten.co.jp/@0_mall/t-interior/cabinet/item/usual/htc50_bp2.jpg?_ex=300x300)
[SS限定]全品5%OFFクーポン 【新商品】 NERUS ふわとろ毛布 Air AirPremium 【正規品】 毛布 ブランケット もこもこ毛布 モコモコ とろとろ ふわふわ シングル…

財經理財美食旅遊娛樂人物新聞深探動態雜誌財經理財美食旅遊娛樂人物新聞深探動態雜誌【寒食節吃冷菜】韓國媽媽的偷懶密技 變身超誘人冷吃美食

中が透けない 壁付き チェスト スリム/ワイド 幅34/54 奥行41.5/41.7 高さ66.1/86.1/106.1cm タンス 衣装ケース 収納ケース プラスチック 引き出し 洗面所 収納…

【スーパーSALE期間73%OFF 12/4 20時〜】ラグマット 厚手 極厚25mm 2畳 3畳 洗える フランネル 防音 滑り止め付 床暖房 ホットカーペット対応 こたつ 対応 高反発ラグ…

寒食節、Banh troi(バインチョーイ)とBanh chay(バインチャイ)

【LIVEエントリーP5倍】 【“5年連続”インテ寝具総合1位】確かな品質 「純」 高反発(R) 〈全部洗える〉 マットレス 10cm厚 3つ折り 折りたたみ ベッドマットレス 10cm…

清明節寒食節伝統的なカスタム青年グループのイラスト写真無料ダウンロード

寒食節、Banh troi(バインチョーイ)とBanh chay(バインチャイ)

【タイムセール1,456円〜!3点購入クーポンで!】高品質 毛布 ふわとろ毛布 もこもこ毛布 ブランケット モコモコ とろとろ ふわふわ ハーフ シングル セミダブル ダブル ふわもこ ひざ掛け…

ベトナムの寒食節バインチョーイ・バインチャイ(Bánh trôi、Bánh chay)

【半額以下★更に3点目50%クーポン】 \楽天1位&8万枚突破/ 掛け布団 シングル 布団 冬 羽毛布団のように 暖かい シングル 掛け布団 ダブル セミダブル 掛け布団 冬用…

【77%OFFクーポンで570円】【総合ランキング1位 】収納ボックス 折畳み キャスター付き 5面開閉 収納ケース 押入れ収納 組立簡単 27L/40L/53L/82L 積み重ね…
![[クーポンで20%OFF] [即日出荷] [レビュー11000件超え/高評価4.59点] 毛布 シングル 140×200cm ブランケット 冬 ひざ掛け 膝掛け 掛け毛布 160×200cm 180×200cm レギュラー ボリュームタイプ 4層プレミアム マイクロファイバー フランネル セミダブル ダブル 暖かい](https://thumbnail.image.rakuten.co.jp/@0_mall/dondon/cabinet/zmf01_3.jpg?_ex=300x300)
[クーポンで20%OFF] [即日出荷] [レビュー11000件超え/高評価4.59点] 毛布 シングル 140×200cm ブランケット 冬 ひざ掛け 膝掛け 掛け毛布 160×200cm…

★楽天スーパーSALE限定最大16%OFF★~11日1:59!見逃し厳禁★掛け布団 洗える 布団 シングル セミダブル ダブル シンサレート 暖かい 洗濯 丸洗い 軽量 軽い 冬 冬用 冬掛け布団…

コージンバイオ株式会社 食品工場で多数実績あり『卵黄加マンニット食塩寒天培地』

栄研 E―KE08|||マンニット食塩培地 分包顆粒/英贤E-KE08 | | |甘露醇盐琼脂袋颗粒栄研 E―KE08|||マンニット食塩培地 分包顆粒-36-0411

【日本No.1受賞】ハグモッチ 正規品【さらに改善】【医師の92%推奨】30万人の眠りを変えた 枕 ふわもち 腰 肩 首 いびき防止 抱き枕 妊婦 誕生日プレゼント 人をダメにする クッション…

Incident ID: 2443b682-bohn-42df-a556-7e678161893d IP Address : 219.104.25.38

ラグ 洗える 1畳 1.5畳 2畳 3畳 4畳 洗えるラグ おしゃれ 北欧 防ダニ 冬 床暖房対応 オールシーズン 滑り止め マット ラグマット カーペット ラグカーペット センターラグ 正方形…

Incident ID: 0816b24e-bohn-4228-8462-d62632b30363 IP Address : 219.104.25.38
Incident ID: 076522dc-bohn-4a8b-8f51-60113472603d IP Address : 219.104.25.38

\P5倍 楽天スーパーSALE半額50%OFF 1000円ポッキリ 4個以上でイーゼルプレゼント/フォトパネル 写真プリント キャンバス 印刷 写真パネル 20cm×20cm 完全データ入稿…

キーワード解説実業団連盟への新規チーム登録について2015年度硫黄島訪島事業 ガイダンス【紫外線注意報発令中です】そ の 他編レシピはこちらPDFファイルへのリンクですチラシ - 一般社団法人 日本理科教育学会自動小口染色システムの実用化試験2009年10月 - 日本サーバス小学校5年生「もののとけ方」教師用 - 国土交通省講演会「福島廃炉、環境回復に関する化学研究開発の最前線およびそのローヤルゼリー Royal Jelly - Nu Skin横浜ロイヤルパークホテル ご宿泊オプション血漿分画製剤(人血清アルブミン製剤)【11月5日】 新ディスポーザブル・プラスチックピペット追加販売のお知らせJA-10 -1 - ベックマン・コールターPDFダウンロードはこちら新ひだかソーラーパーク ニュースリリースのご案内 NEW!EMの増やし方 ①sCLARITYJLA-8.1000 - ベックマン・コールターexpydoc.comYour ExpyDoc

アスクルオリエンタル酵母工業 食品用寒天平板生培地 卵黄加マンニット 1箱(100枚) 6-9729-13(直送品)

未分類 暇をみてNO①寒天培地を作ってみました。 おすすめこのサイトについて

【★ポイント3倍&200円OFFクーポン】【一部カラー20%引!】 販売累計12.9万枚! ラグ 洗える シエロ ラグマット キルトラグ 絨毯 北欧 おしゃれ くすみ カーペット 95×130…